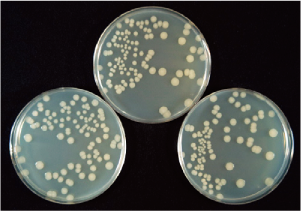

印刷
ページ番号:11161
更新日:2026年2月27日
ここから本文です。
特集2
県民だより奈良
2020年10月号
特集2
「奈良の木」を暮らしに!~1人1人の「木づかい」で森林を次の世代につなげよう~

10月は木材を使うこと(木づかい)を推進する「奈良の木づかい運動推進月間」です。
奈良県は県の面積のおよそ77パーセントが森林です。また、500年以上も林業が受け継がれており、森林と深いつながりがあります。
今回の特集では、奈良の木の特長や暮らしに木を取り入れる「木づかい」のヒント、木づかいと森林の関係についてご紹介します。
長い歴史を持つ奈良の林業
奈良の林業の歴史は古く、室町時代から植林が行われており、大坂城や伏見城にも奈良の木が使われました。木の育て方は地域ごとに違いますが、吉野林業(主に川上村・東吉野村・黒滝村)では、密植(密に植える)や定期的な枝打ち・間伐を行い、長い時間と手間暇をかけて木を育てます。

植栽

枝打ち

間伐

主伐

奈良県の植栽
8,000~12,000本/ha

一般的な植栽
3,000本/ha
奈良の木は多くの時間と手間暇をかけて大切に育てられているんだ!

まず「奈良の木」を知ろう!
奈良の木の特長
奈良の木ってどんな特長があるの?
木を使うといいことってあるのかな?


年輪幅が狭く、均一

幹の根元から先端までの太さが一定

節が少なく色合いが美しい
奈良の木の健康効果
県では、奈良の木の健康効果を科学的に検証するため、県産のスギとヒノキを材料に実験を行いました。
その1 菌が増えにくい
検証方法
県産のスギ材・ヒノキ材の精油を、寒天培地に添加。大腸菌を接種して生育状況を2日間観察。
増殖×
精油の添加なし
増殖防止○

県産スギ精油1%添加
増殖防止○

県産ヒノキ精油5%添加
結果
県産のスギ材・ヒノキ材の精油添加で大腸菌の増殖を阻止しました。
その2 室内の湿度調節
検証方法
県産のスギ・ヒノキ板を温度23℃・相対湿度40%で調湿した後、高湿度環境(80%)と低湿度環境(40%)で2日間置き、その間、板に含まれる水分量を測定。

結果
県産のスギ材・ヒノキ材は、高湿度環境で湿気を吸い込み、低湿度環境で湿気をはき出しました。
ほかにもこんな効果が・・・
- ウイルスの感染力が低下
※インフルエンザウイルスA型で検証 - カビが生えにくい
- ダニが近づかない
- においを減らす(消臭)
- 熱を伝えにくい
- 紫外線の軽減 など
奈良の木を使うをいいことがたくさんあるんだね!

「木」の専門家に聞く奈良の木の魅力
奈良の木は、強度も美観も備えた優れもの。県では、素材の良さを生かした新しい用途を研究しています。無垢(むく)防音フローリングもその1つ。切れ込み加工とクッション材の組み合わせで高い防音性能を実現しました。階下への騒音が気になるマンションなどにおすすめです。

県森林技術センター
木材利用課 酒井課長

無垢防音フローリング
※県内で製造販売しています
「奈良の木」がある暮らし
最近、テレワークの導入などで家で過ごす時間が増えています。
「木」を暮らしに取り入れることで「おうち時間」を快適に過ごしてみませんか?
生活雑貨
木の小物は、気軽に取り入れやすくてオススメ。







家具・インテリア
良質な奈良の木を使った家具は一生モノ。
お気に入りのデザインを探すのも楽しい♪




住宅・リフォーム
木の空間で過ごす毎日。
最近ではリフォームでの木材利用も増えています!
新築



リフォーム
もっと「奈良の木」を知るなら
奈良の木づかいフェスタ
- 時 10月3日(土曜日)・4日(日曜日)
- 所 イオンモール大和郡山

奈良県児童生徒木工工作展、木工ワークショップ、パネル展示などで奈良の木について学べます。
ポータルサイト「奈良の木のこと」

奈良の木の情報が満載!
奈良の木のこと
実際に見てみよう♪「奈良の木」が使われている県内スポット

奈良 蔦屋書店
(奈良市)

奈良県コンベンションセンター
(奈良市)

平城宮跡歴史公園朱雀門ひろば
天平みつき館(奈良市)
engawaでは奈良の木を使った小物や家具を販売♪

奥大和移住定住交流センター
engawa(橿原市)
- 問 県奈良の木ブランド課
- 電話 0742-27-7470
- FAX 0742-27-1070
1人1人の「木づかい」が森林を守ることにつながる
木を使うこと(木づかい)は森林環境の維持向上につながる
どうして木を使うこと(木づかい)が、森を守ることにつながるの?

奈良の木を使うことで、「植える、育てる、収穫する、使う」という未来につながる森林の持続的なサイクルが保たれます。森林を育てるお金が山に還元され、枝打ちや間伐などが進むことで、森林環境の維持向上につながります。
奈良の木を使って豊かな森林を育てましょう。

森林環境を維持向上させるための新たな取り組み(森林環境管理制度)
県は、スイスの林業を参考にした県独自の「新たな森林環境管理制度」を導入しています。
奈良県フォレスター(市町村で森林管理に携わる県職員)が森林の4機能を一元管理し、適正人工林、恒続林、自然林、天然林へ誘導することにより、森林と人とが恒久的に共生することを目指しています。
また、「奈良県フォレスターアカデミー」を令和3年4月に開校します。
森林の4機能

防災機能
- 木の根が土砂や岩石などを固定して、土砂の崩壊を防止
- 降雨を地下に蓄え、少しずつ流すことにより洪水を緩和

生物多様性保全機能
- 多様な動植物の生育・生息の場を提供

レクリエーション機能
- 景観の保全や教育・芸術の場を提供
- 健康の維持・増進やレクリエーション活動の場の提供

森林資源生産機能
- 木材やきのこ、きれいな水を供給
- 二酸化炭素を吸収し、炭素を貯蔵することにより地球温暖化を防止

木を使うと、森林環境の維持向上につながるのね!

令和3年4月にいよいよ開校!奈良県フォレスターアカデミー Nara Forester Academy
奈良県フォレスターアカデミーは、奈良県独自の「新たな森林環境管理制度」を担い、「奈良の木」を次の世代に引き継いでいく人材の養成機関です。

フォレスター学科
(修業期間:2年間)

学べること
- 森林作業に必要な基本的な技術や技能
- 森林に関する高度な専門知識と幅広い基礎能力
(経営・サポート・コミュニケーション・リーダーシップ)
卒業後の進路
- 森林組合や林業事業体(幹部候補)
- 奈良県フォレスターなど
森林作業員学科
(修業期間:1年間)

学べること
- 森林作業に必要な高度な技術や技能
- 労働安全衛生や森林に関する専門知識
卒業後の進路
- 森林組合や林業事業体(現場責任者候補)
入学希望者の募集がはじまります!!
定員
- フォレスター学科 5人程度
- 森林作業員学科 10人程度
試験情報
受験資格
令和3年4月1日時点の年齢が18歳以上で林業の実務に耐えうる健康状態を有し、高等学校卒業(卒業見込み)程度
第1回試験
【出願期間】11月6日(金曜日)~12月4日(金曜日)
【試験日】12月13日(日曜日)
【合格発表】12月21日(月曜日)
※第2回以降の試験については、下記HPへ掲載
URL www.pref.nara.jp/46680.htm
学費など
- 入学料:5,650円
- 年間授業料:118,800円
- その他経費:250,000円程度
緑の青年就業準備給付金
「修業支援制度」もあります!
林業大学校など、林業分野への就業に必要な知識・技術などを習得する青年に対して、在学期間中、最大155万円/年(最長2年間)を給付する国の制度です。
学校所在地
吉野町飯貝(現 県立吉野高等学校地内)

- 問 県森と人の共生推進室
- 電話 0742-27-8115
- FAX 0742-24-5004